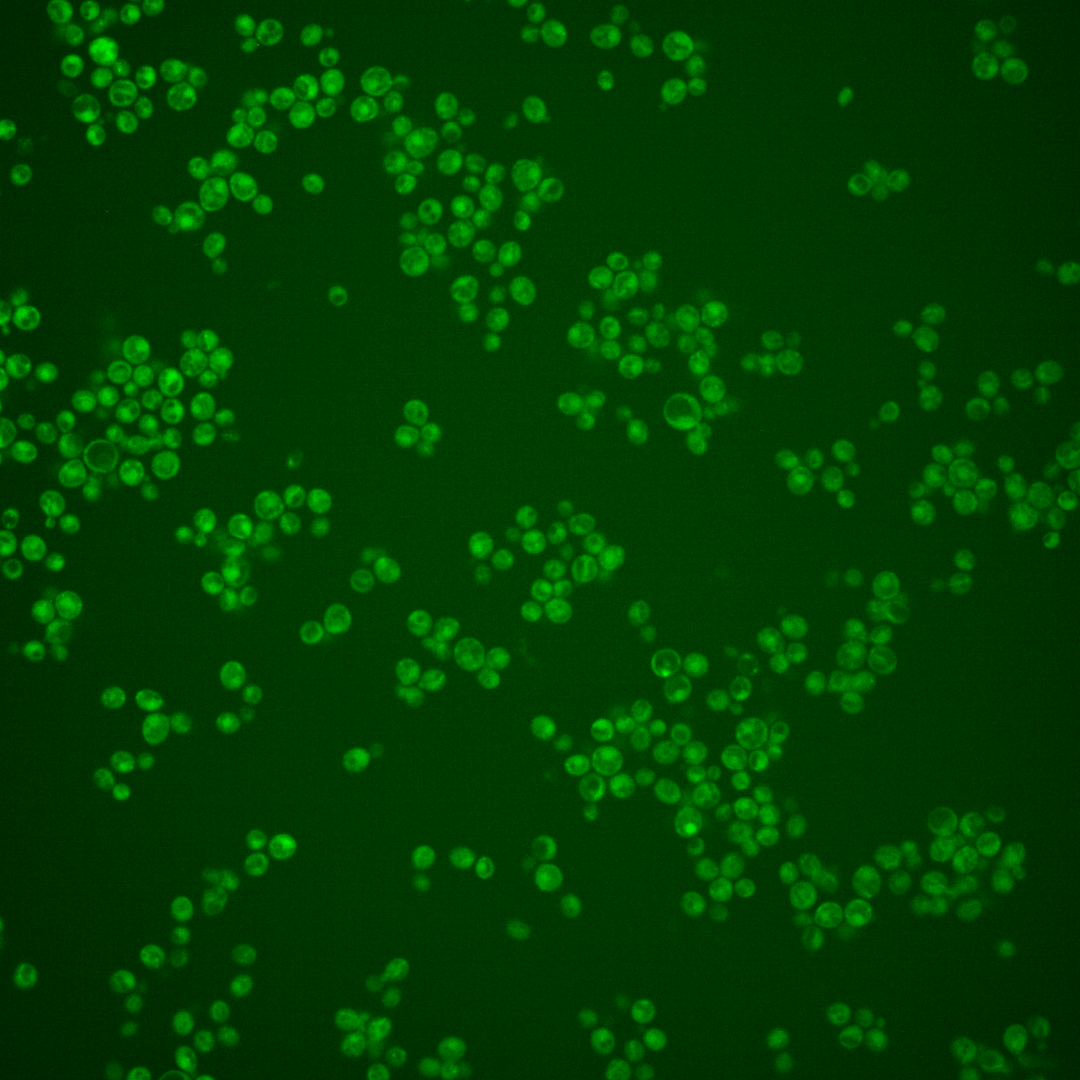
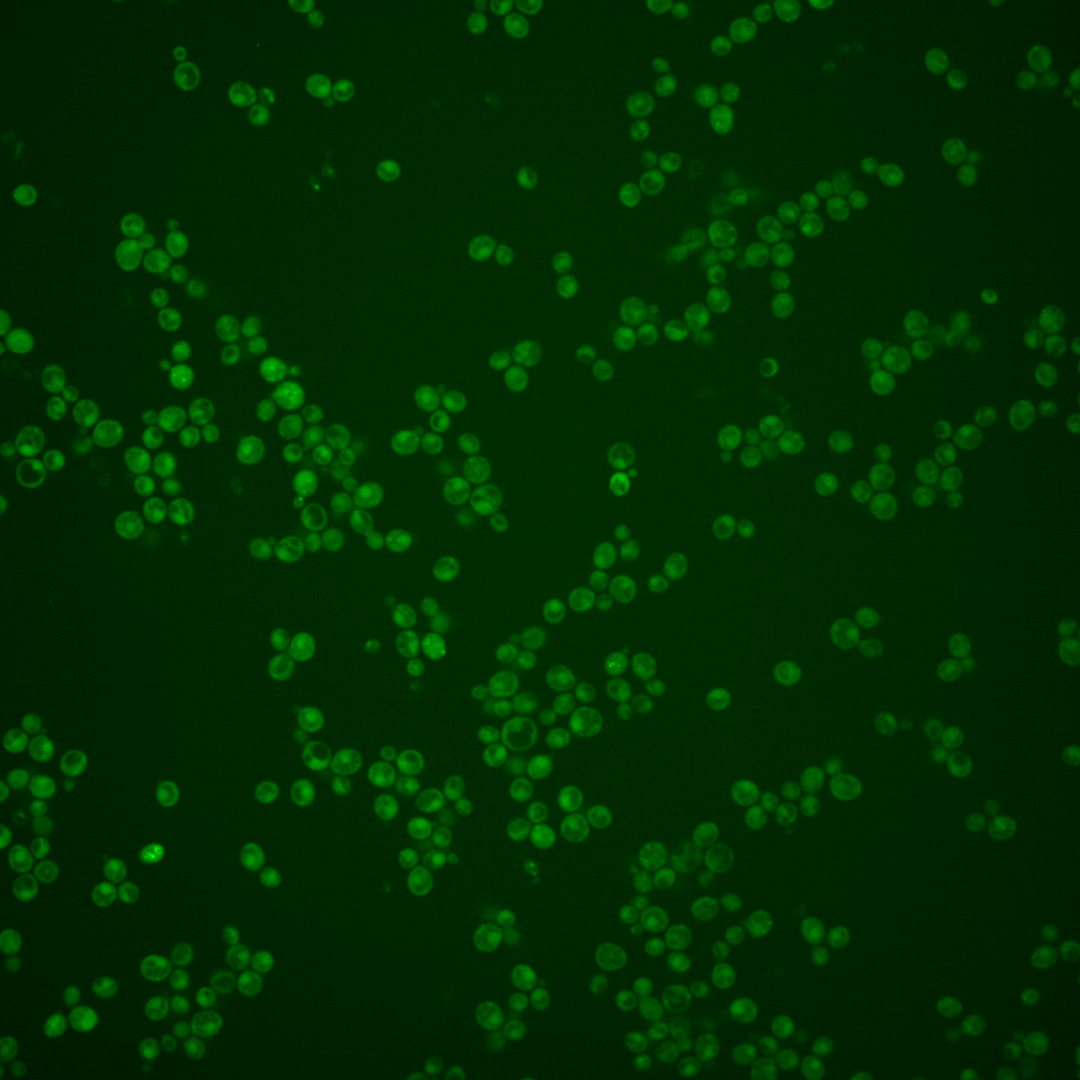
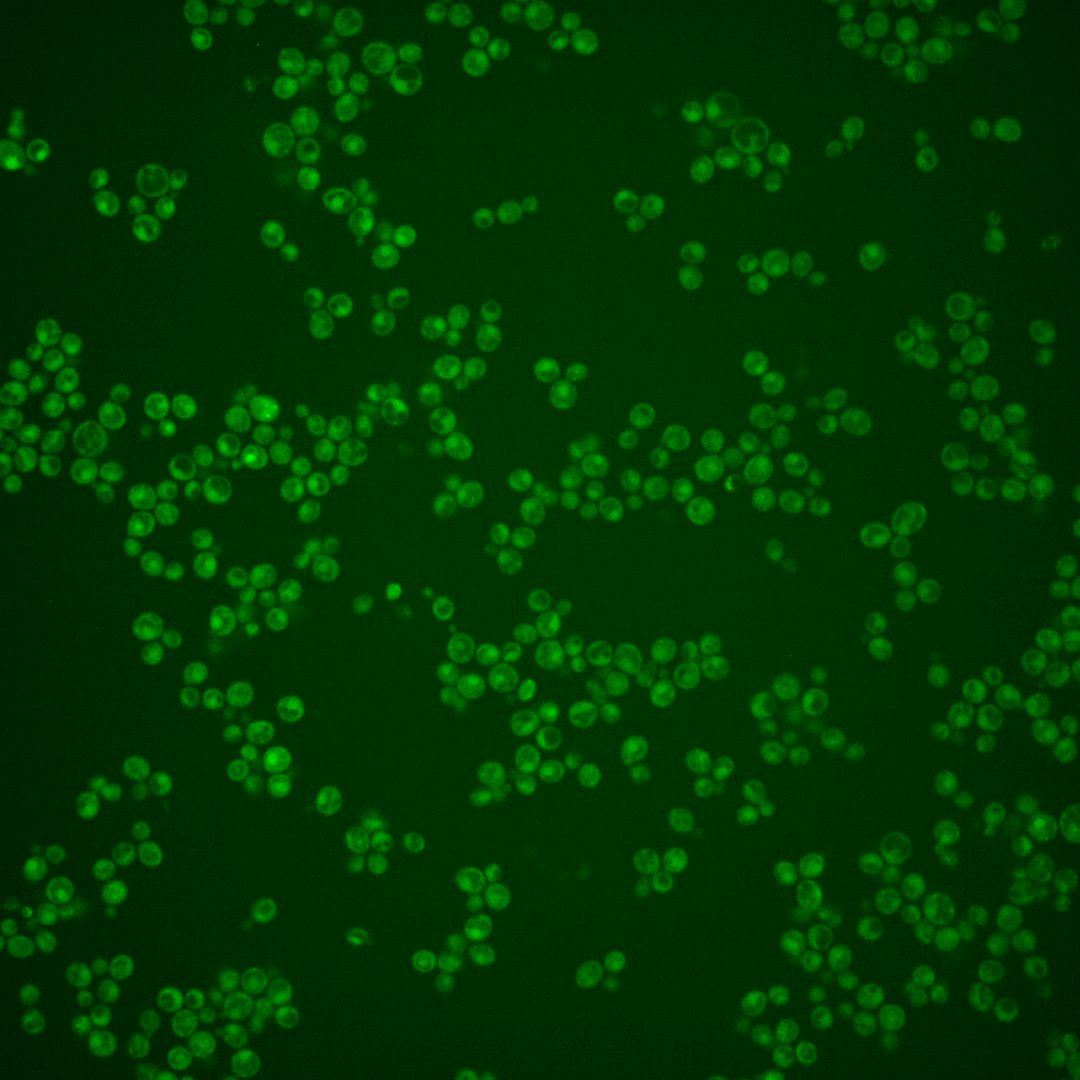

| Standard name | |
|---|---|
| Human Ortholog | |
| Description | UDP-glycosyltransferase subunit of the GPI-GnT complex; UDP-GlcNAc-binding and catalytic subunit of the enzyme that mediates the first step in glycosylphosphatidylinositol (GPI) biosynthesis, mutations cause defects in transcription and in biogenesis of cell wall proteins |
Micrographs




















































































Sub-cellular Localization
Yeast GFP Assignment
Protein Abundance
Localization Change
External localization resources
| ensLOC | DeepLoc | |||||||||||||||||||||||
|---|---|---|---|---|---|---|---|---|---|---|---|---|---|---|---|---|---|---|---|---|---|---|---|---|
| Localization | WT1 | WT2 | WT3 | RAP60 | RAP140 | RAP220 | RAP300 | RAP380 | RAP460 | RAP540 | RAP620 | RAP700 | HU80 | HU120 | HU160 | rpd3Δ_1 | rpd3Δ_2 | rpd3Δ_3 | WT1 | WT2 | WT3 | AF100 | AF140 | AF180 |
| Cortical Patches | 0 | 0 | 0 | 0 | 0 | 0 | 1 | 0 | – | 0 | 0 | 0 | 0 | 0 | 0 | – | 0 | 0 | 2 | 2 | 7 | 3 | 1 | 4 |
| Bud | 0 | 2 | 3 | 0 | 1 | 0 | 2 | 1 | – | 1 | 5 | 6 | 0 | 0 | 0 | – | 0 | 0 | 0 | 4 | 1 | 4 | 3 | 2 |
| Bud Neck | 0 | 0 | 2 | 0 | 1 | 0 | 0 | 1 | – | 1 | 0 | 2 | 0 | 1 | 0 | – | 7 | 0 | 0 | 2 | 2 | 2 | 2 | 3 |
| Bud Site | 0 | 0 | 0 | 0 | 0 | 0 | 0 | 0 | – | 0 | 2 | 0 | 0 | 0 | 0 | – | 0 | 0 | – | – | – | – | – | – |
| Cell Periphery | 0 | 0 | 0 | 3 | 1 | 1 | 2 | 3 | – | 4 | 1 | 2 | 1 | 1 | 1 | – | 4 | 8 | 2 | 1 | 3 | 3 | 1 | 2 |
| Cytoplasm | 58 | 231 | 223 | 126 | 117 | 174 | 160 | 181 | – | 142 | 159 | 167 | 84 | 84 | 120 | – | 451 | 281 | 56 | 186 | 172 | 82 | 106 | 106 |
| Endoplasmic Reticulum | 1 | 2 | 1 | 1 | 4 | 2 | 0 | 1 | – | 1 | 1 | 7 | 0 | 0 | 1 | – | 37 | 21 | 30 | 2 | 8 | 5 | 5 | 2 |
| Endosome | 2 | 0 | 0 | 1 | 1 | 1 | 0 | 0 | – | 3 | 3 | 2 | 1 | 0 | 0 | – | 1 | 2 | 5 | 5 | 3 | 1 | 1 | 1 |
| Golgi | 1 | 1 | 0 | 0 | 0 | 0 | 0 | 0 | – | 0 | 0 | 0 | 0 | 0 | 0 | – | 0 | 0 | 1 | 1 | 0 | 2 | 1 | 0 |
| Mitochondria | 6 | 11 | 5 | 7 | 3 | 31 | 74 | 65 | – | 84 | 157 | 172 | 2 | 2 | 0 | – | 15 | 7 | 9 | 13 | 26 | 11 | 13 | 13 |
| Nucleus | 1 | 3 | 0 | 1 | 0 | 0 | 0 | 0 | – | 0 | 0 | 1 | 1 | 1 | 0 | – | 1 | 3 | 0 | 0 | 0 | 1 | 0 | 0 |
| Nuclear Periphery | 0 | 1 | 0 | 0 | 0 | 0 | 0 | 1 | – | 1 | 0 | 0 | 0 | 0 | 0 | – | 0 | 0 | 0 | 0 | 0 | 0 | 0 | 0 |
| Nucleolus | 1 | 1 | 0 | 0 | 0 | 0 | 0 | 0 | – | 0 | 1 | 0 | 0 | 0 | 0 | – | 0 | 0 | 0 | 0 | 0 | 0 | 0 | 0 |
| Peroxisomes | 0 | 0 | 0 | 0 | 0 | 0 | 1 | 1 | – | 1 | 0 | 0 | 0 | 0 | 1 | – | 0 | 0 | 0 | 0 | 0 | 0 | 0 | 0 |
| SpindlePole | 0 | 0 | 1 | 0 | 1 | 0 | 0 | 1 | – | 2 | 6 | 6 | 0 | 0 | 0 | – | 0 | 0 | 0 | 1 | 2 | 0 | 1 | 1 |
| Vac/Vac Membrane | 1 | 0 | 0 | 0 | 1 | 2 | 1 | 2 | – | 2 | 3 | 2 | 1 | 2 | 0 | – | 2 | 1 | 9 | 5 | 3 | 1 | 5 | 4 |
| Unique Cell Count | 67 | 241 | 227 | 131 | 126 | 188 | 199 | 224 | 199 | 264 | 293 | 89 | 88 | 121 | 460 | 290 | 126 | 238 | 239 | 123 | 152 | 149 | ||
| Labelled Cell Count | 71 | 252 | 235 | 139 | 130 | 211 | 241 | 257 | 242 | 338 | 367 | 90 | 91 | 123 | 518 | 323 | 126 | 238 | 239 | 123 | 152 | 149 | ||
Yeast GFP Assignment
Protein Abundance
| Screen | WT1 | WT2 | WT3 | RAP60 | RAP140 | RAP220 | RAP300 | RAP380 | RAP460 | RAP540 | RAP620 | RAP700 | HU80 | HU120 | HU160 | rpd3Δ_1 | rpd3Δ_2 | rpd3Δ_3 | AF100 | AF140 | AF180 |
|---|---|---|---|---|---|---|---|---|---|---|---|---|---|---|---|---|---|---|---|---|---|
| Mean Cell GFP Intensity (1e-4) | 3.9 | 4.0 | 3.7 | 3.6 | 3.6 | 3.2 | 2.9 | 3.3 | – | 2.9 | 3.0 | 2.8 | 5.3 | 5.3 | 5.3 | 4.3 | 5.1 | 5.7 | 5.0 | 5.9 | 6.4 |
| Std Deviation (1e-4) | 0.9 | 1.0 | 1.2 | 0.9 | 0.8 | 1.0 | 0.9 | 1.3 | – | 0.7 | 1.4 | 0.9 | 1.4 | 1.4 | 0.7 | 1.1 | 1.4 | 1.5 | 1.7 | 2.4 | 3.2 |
| Intensity Change (Log2) | – | – | – | -0.01 | -0.03 | -0.21 | -0.35 | -0.13 | – | -0.34 | -0.26 | -0.38 | 0.53 | 0.53 | 0.55 | 0.22 | 0.47 | 0.64 | 0.46 | 0.69 | 0.8 |
Localization Change
| Localization | RAP60 | RAP140 | RAP220 | RAP300 | RAP380 | RAP460 | RAP540 | RAP620 | RAP700 | HU80 | HU120 | HU160 | rpd3Δ_1 | rpd3Δ_2 | rpd3Δ_3 |
|---|---|---|---|---|---|---|---|---|---|---|---|---|---|---|---|
| Actin | – | – | – | – | – | – | – | – | – | – | – | – | – | – | – |
| Bud | – | – | – | – | – | – | – | – | – | – | – | – | – | – | – |
| Bud Neck | – | – | – | – | – | – | – | – | – | – | – | – | – | – | – |
| Bud Site | – | – | – | – | – | – | – | – | – | – | – | – | – | – | – |
| Cell Periphery | – | – | – | – | – | – | – | – | – | – | – | – | – | – | – |
| Cyto | – | – | – | – | – | – | – | – | – | – | – | – | – | – | – |
| Endoplasmic Reticulum | – | – | – | – | – | – | – | – | – | – | – | – | – | – | – |
| Endosome | – | – | – | – | – | – | – | – | – | – | – | – | – | – | – |
| Golgi | – | – | – | – | – | – | – | – | – | – | – | – | – | – | – |
| Mitochondria | – | – | – | – | – | – | – | – | – | – | – | – | – | – | – |
| Nuclear Periphery | – | – | – | – | – | – | – | – | – | – | – | – | – | – | – |
| Nuc | – | – | – | – | – | – | – | – | – | – | – | – | – | – | – |
| Nucleolus | – | – | – | – | – | – | – | – | – | – | – | – | – | – | – |
| Peroxisomes | – | – | – | – | – | – | – | – | – | – | – | – | – | – | – |
| SpindlePole | – | – | – | – | – | – | – | – | – | – | – | – | – | – | – |
| Vac | – | – | – | – | – | – | – | – | – | – | – | – | – | – | – |
| Cortical Patches | – | – | – | – | – | – | – | – | – | – | – | – | – | – | – |
| Cytoplasm | – | – | – | – | – | – | – | – | – | – | – | – | – | – | – |
| Nucleus | – | – | – | – | – | – | – | – | – | – | – | – | – | – | – |
| Vacuole | – | – | – | – | – | – | – | – | – | – | – | – | – | – | – |
External localization resources
Images






























Protein Concentration and Protein Localization Data
| R1 | R2 | R3 | ||||||||||||||||
|---|---|---|---|---|---|---|---|---|---|---|---|---|---|---|---|---|---|---|
| G1 Pre-START | G1 Post-START | S/G2 | Metaphase | Anaphase | Telophase | G1 Pre-START | G1 Post-START | S/G2 | Metaphase | Anaphase | Telophase | G1 Pre-START | G1 Post-START | S/G2 | Metaphase | Anaphase | Telophase | |
| Concentration | 1.5293 | 0.2146 | 0.7666 | -0.1039 | 0.8384 | 0.564 | 2.5114 | 1.8784 | 2.289 | 2.2713 | 2.3017 | 2.1726 | 1.8236 | 1.9937 | 1.5819 | 2.0437 | 1.7681 | 1.7809 |
| Actin | 0.0627 | 0.0011 | 0.0008 | 0.0004 | 0.005 | 0.0003 | 0.0455 | 0.0005 | 0.0074 | 0.0002 | 0.0346 | 0.0046 | 0.0312 | 0.0001 | 0.0144 | 0.0002 | 0.0211 | 0.0049 |
| Bud | 0.001 | 0.0012 | 0.0003 | 0.0001 | 0.006 | 0 | 0.0007 | 0.0031 | 0.0007 | 0.002 | 0.0008 | 0.0002 | 0.0003 | 0 | 0.0023 | 0 | 0.0003 | 0.0001 |
| Bud Neck | 0.015 | 0.0002 | 0 | 0.0001 | 0.0011 | 0.0005 | 0.0151 | 0.0002 | 0.0002 | 0.0001 | 0.0004 | 0.0004 | 0.003 | 0.0001 | 0.0002 | 0 | 0.0005 | 0.0001 |
| Bud Periphery | 0.0018 | 0.0008 | 0.0005 | 0.0001 | 0.0118 | 0 | 0.0013 | 0.0055 | 0.001 | 0.0004 | 0.001 | 0.0009 | 0.0009 | 0 | 0.0052 | 0 | 0.0005 | 0.0002 |
| Bud Site | 0.0197 | 0.0127 | 0.0001 | 0 | 0.0631 | 0 | 0.0218 | 0.0088 | 0.0021 | 0.0004 | 0.0019 | 0.0001 | 0.0033 | 0.0006 | 0.0021 | 0 | 0.001 | 0.0002 |
| Cell Periphery | 0.0018 | 0.0003 | 0.0001 | 0.0001 | 0.0026 | 0.0001 | 0.0008 | 0.0004 | 0.0003 | 0.0002 | 0.0001 | 0.0001 | 0.0004 | 0.0002 | 0.0003 | 0.0001 | 0.0002 | 0 |
| Cytoplasm | 0.0442 | 0.0409 | 0.0599 | 0.0167 | 0.1027 | 0.0552 | 0.0849 | 0.0961 | 0.1637 | 0.1955 | 0.1581 | 0.2082 | 0.1391 | 0.1264 | 0.139 | 0.162 | 0.1873 | 0.1393 |
| Cytoplasmic Foci | 0.0242 | 0.0109 | 0.0051 | 0.0041 | 0.0074 | 0.002 | 0.0287 | 0.0063 | 0.0141 | 0.0121 | 0.0178 | 0.0187 | 0.0102 | 0.0025 | 0.0104 | 0.0046 | 0.0038 | 0.004 |
| Eisosomes | 0.0017 | 0.0006 | 0.0004 | 0.0003 | 0.0004 | 0.0001 | 0.0003 | 0.0001 | 0.0004 | 0.0001 | 0.0005 | 0.0001 | 0.0005 | 0.0002 | 0.0007 | 0.0001 | 0.0004 | 0.0002 |
| Endoplasmic Reticulum | 0.005 | 0.0012 | 0.0034 | 0.0012 | 0.0017 | 0.0019 | 0.0087 | 0.0018 | 0.0058 | 0.0097 | 0.0021 | 0.0074 | 0.0113 | 0.0019 | 0.0034 | 0.0045 | 0.0031 | 0.0022 |
| Endosome | 0.0259 | 0.001 | 0.0021 | 0.0006 | 0.0224 | 0.0003 | 0.0274 | 0.0021 | 0.0071 | 0.0024 | 0.004 | 0.0075 | 0.0072 | 0.0006 | 0.0015 | 0.0027 | 0.0045 | 0.0036 |
| Golgi | 0.0101 | 0.0002 | 0.0003 | 0.0001 | 0.0043 | 0 | 0.0044 | 0.0002 | 0.009 | 0.0001 | 0.0066 | 0.0043 | 0.0024 | 0.0001 | 0.0009 | 0.0001 | 0.0018 | 0.0018 |
| Lipid Particles | 0.0225 | 0.0007 | 0.001 | 0.0014 | 0.0303 | 0.0001 | 0.0078 | 0.0011 | 0.0034 | 0.0005 | 0.0027 | 0.0109 | 0.005 | 0.0002 | 0.0024 | 0.0004 | 0.0019 | 0.0016 |
| Mitochondria | 0.012 | 0.0003 | 0.0006 | 0.0002 | 0.0456 | 0.0001 | 0.0021 | 0.0004 | 0.0155 | 0.0144 | 0.0221 | 0.0044 | 0.0012 | 0.0001 | 0.002 | 0.0002 | 0.0011 | 0.0085 |
| None | 0.644 | 0.9235 | 0.9205 | 0.9726 | 0.6287 | 0.9381 | 0.6966 | 0.8698 | 0.7559 | 0.7538 | 0.7356 | 0.7133 | 0.7623 | 0.8649 | 0.7957 | 0.8229 | 0.7652 | 0.8291 |
| Nuclear Periphery | 0.025 | 0.0004 | 0.0012 | 0.0008 | 0.0134 | 0.0002 | 0.0206 | 0.0005 | 0.0016 | 0.001 | 0.0004 | 0.0021 | 0.0043 | 0.0003 | 0.0008 | 0.0006 | 0.0036 | 0.0004 |
| Nucleolus | 0.0035 | 0.0003 | 0.0002 | 0.0001 | 0.0013 | 0 | 0.0009 | 0.0003 | 0.0005 | 0.0025 | 0.0004 | 0.0001 | 0.001 | 0.0001 | 0.0002 | 0.0001 | 0.0002 | 0 |
| Nucleus | 0.0196 | 0.0007 | 0.0007 | 0.0002 | 0.0022 | 0.0004 | 0.0067 | 0.0006 | 0.0014 | 0.0021 | 0.0005 | 0.0007 | 0.002 | 0.0009 | 0.0005 | 0.0005 | 0.001 | 0.0004 |
| Peroxisomes | 0.0173 | 0.0007 | 0.0007 | 0.0003 | 0.0414 | 0.0001 | 0.0061 | 0.0002 | 0.0051 | 0.0005 | 0.0077 | 0.0126 | 0.0064 | 0 | 0.0143 | 0.0001 | 0.0003 | 0.0021 |
| Punctate Nuclear | 0.0381 | 0.0016 | 0.0007 | 0.0004 | 0.0024 | 0.0002 | 0.0075 | 0.001 | 0.0036 | 0.0006 | 0.002 | 0.0014 | 0.006 | 0.0003 | 0.0029 | 0.0005 | 0.0011 | 0.0004 |
| Vacuole | 0.0034 | 0.0007 | 0.001 | 0.0003 | 0.0033 | 0.0003 | 0.0081 | 0.0012 | 0.001 | 0.0012 | 0.0004 | 0.0012 | 0.0016 | 0.0006 | 0.0005 | 0.0004 | 0.0006 | 0.0005 |
| Vacuole Periphery | 0.0015 | 0.0001 | 0.0002 | 0.0001 | 0.003 | 0 | 0.0043 | 0.0001 | 0.0004 | 0.0003 | 0.0002 | 0.0005 | 0.0004 | 0 | 0.0001 | 0.0001 | 0.0004 | 0.0002 |
Sequencing Data
| R1 | R2 | |||||||||
|---|---|---|---|---|---|---|---|---|---|---|
| G1 Post-START | S/G2 | Metaphase | Anaphase | Telophase | G1 Post-START | S/G2 | Metaphase | Anaphase | Telophase | |
| Gene Expression | 10.149 | 7.2581 | 10.7717 | 12.2182 | 11.5796 | 8.1147 | 12.1088 | 12.6304 | 11.8932 | 15.5829 |
| Translational Efficiency | 0.8246 | 0.768 | 0.5046 | 0.424 | 0.6565 | 0.689 | 0.5416 | 0.3484 | 0.4569 | 0.5056 |
Hit Data
| Dataset | Hit |
|---|---|
| Protein Concentration | ✘ |
| Protein Localization | ✘ |
| Gene Expression | ✘ |
| Translational Efficiency | ✔ |
Endocytosis
| Temp | Actin Patch (Sac6-tdTomato) | Cortical Patch (Sla1-GFP) | Late Endosome (Snf7-GFP) | Vacuole (Vph1-GFP) |
|---|---|---|---|---|
| 37℃ | ||||
| RT |
Cell Cycle Omics
CYCLoPs (Spt14-GFP)
| Gene / Allele | Actin Patch (Sac6-tdTomato) | Cortical Patch (Sla1-GFP) | Late Endosome (Snf7-GFP) | Vacuole (Sac6-tdTomato) |
|---|
| Gene | Images |
|---|
| Gene | Images |
|---|
Images are not yet available
Images are not yet available